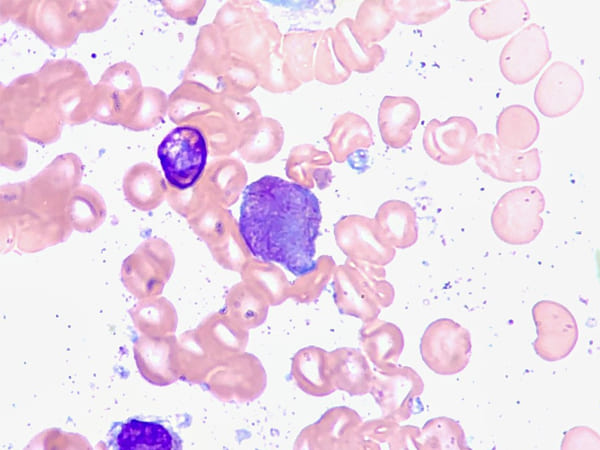
क्रोनिक ल्यूकेमिया-
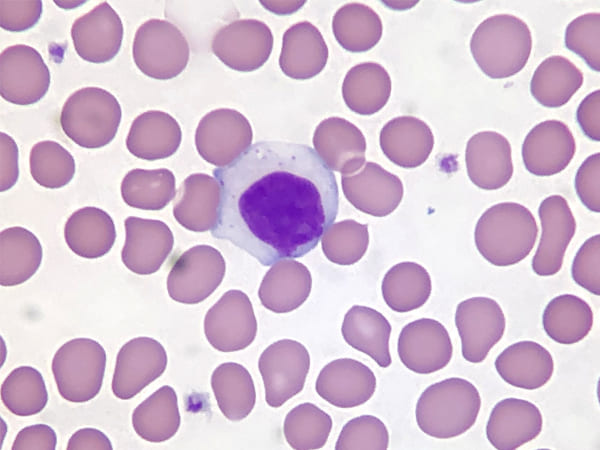
मायलोजनस ल्यूकेमिया-

Latest Updates
-
Quick Filling Dinner Anda Paratha Recipe: घर पर बनाएं ढाबे जैसा स्वादिष्ट अंडा पराठा -
मानसून से पहले दिल्ली में डेंगू के 162 और मलेरिया के 42 मामले, कहीं आप भी न हो जाएं शिकार; जानें बचाव के उपाय -
Dhaba Style Marinade Chicken Tikka Recipe: घर पर पाएं रेस्टोरेंट जैसा स्मोकी स्वाद -
प्रेग्नेंट हैं 39 साल की सामंथा रुथ प्रभु! करीबी शख्स ने किया कन्फर्म, जानें कब होगी डिलीवरी -
मलाइका अरोड़ा की फिटनेस का खुल गया राज, 52 की उम्र में यंग दिखने के लिए करती हैं ये 5 योगासन -
South Indian Style Tomato Rice Recipe: घर पर बनाएं रेस्टोरेंट जैसा चटपटा स्वाद -
Summer Solstice: 21 जून को क्यों होता है साल का सबसे बड़ा दिन? जानें क्या है इसके पीछे की असली वजह -
International Yoga Day 2026 Wishes: योग करे जो रोज...योग दिवस पर प्रियजनों को भेजें ये खास शुभकामनाएं -
Father's Day 2026 Shayari: उंगली पकड़कर चलना सिखाया...फादर्स डे पर पापा को भेजें ये दिल छू लेने वाली शायरियां -
Zero Oil Sprouts Cheela Recipe: वजन घटाने के लिए बनाएं हेल्दी और टेस्टी नाश्ता
ल्यूकेमिया से ऋषि कपूर ने हारी जिंदगी की जंग, जानें इस कैंसर के बारे में
अभिनेता इरफान खान के बाद गुरुवार को बॉलीवुड दिग्गज अभिनेता ऋषि कपूर ने 67 साल की उम्र में दुनिया को अलविदा कह दिया। वो ल्यूकेमिया से पीड़ित थे। ऋषि पिछले साल सितंबर में अमेरिका से भारत लौटे थे। वहां करीब एक साल तक उनका कैंसर ट्रीटमेंट चला था। चेस्ट इन्फेक्शन, सांस लेने में दिक्कत और बुखार के कारण बुधवार को उन्हें हॉस्पिटल में भर्ती कराया गया था।

कपूर खानदान की ओर से संदेश जारी कर बताया गया कि गुरुवार सुबह 8.45 बजे ऋषि कपूर ने अंतिम सांस ली। वो ल्यूकेमिया नामक बीमारी से पिछले 2 साल से लड़ रहे थे। आइए जानते है कि ल्यूकेमिया क्या होती है और इसके लक्षण क्या हैं?

क्या होता है ल्यूकेमिया?
ल्यूकेमिया एक प्रकार का ब्लड कैंसर है जिसमें शरीर में सफेद रक्त कोशिकाओं की संख्या असामान्य रूप से बढ़ती हैं और इनके आकार में भी परिवर्तन होता है। ये जमाव स्वस्थ्य रक्त कोशिकाओं के विकास में भी बाधक बनती हैं।

इसके लक्षण
बहुत पसीना आना (विशेष रूप से रात में)- यह ल्यूकेमिया का प्रमुख लक्षण है, जिसमें लोगों को काफी पसीना आता है।
भूख न लगना- अक्सर, भूख न लगने को गंभीरता से नहीं लिया जाता है। लेकिन, कई बार यह किसी गंभीर बीमारी का संकेत हो सकती है।
थकान - अन्य कई परिस्थितियों के अलावा, थकान भी ल्यूकेमिया का एक सामान्य लक्षण है। तो अगर आपको हर वक्त थकान महसूस हो रही है तो
फीवर - ल्यूकेमिया के चलते शरीर में गैर सेहतमंद कोशिकाओं के बढ़ने से आपका इम्यून पावन कम होता है और आप इंफेक्शन और बुखार की चपेट में जल्दी और लगातार आते हैं।
सांसों में कमी - इस बीमारी में जब आप सांस लेते हैं तो ज्यादा गहरी सांस नहीं ले पाते और सांसे छोटी होती हैं। इस तरह से सांसों में कमी होती है।
घाव न भरना - अगर कोई कट लगने या घाव होने के बाद वह लंबे समय तक न भरे, तो यह ल्यूकेमिया का लक्षण हो सकता है।
हड्डियों में दर्द होना- ल्यूकेमिया का अन्य लक्षण हड्डियों में दर्द होना क्योंकि इसकी वजह से हड्डियां कमजोर हो जाती हैं, जिसकी वजह से लोगों को उनमें दर्द होता है।
स्कीन पर लाल दब्बे पड़ना- अक्सर, ल्यूकेमिया के कुछ मामले सामने आते हैं, जिनमें इस कैंसर की शुरूआत स्कीन पर लाल दब्बे के साथ होती है।एक नज़र में यह किसी त्वचा संबंधी परेशान की तरह लग सकते हैं, लेकिन किसी भी नतीजे पर पहुंचने से बेहतर डॉक्टर द्वारा पुष्टि करना है।

चार तरह का होता है ल्यूकेमिया
एक्यूट ल्यूकेमिया
जब बोन मैरो और खून में सैल काफी तेज़ से बढ़ जाते हैं और इकट्ठा हो जाते हैं, तो उसे एक्यूट ल्यूकेमिया कहा जाता है। ये काफी तेज़ी से बोन मैरो में इकट्ठा हो जाते हैं और काम सही तरह से काम नहीं कर पाते हैं।
क्रोनिक ल्यूकेमिया-
जब शरीर में कुछ अविकसित सैल बन जाते हैं और बाकी सैल सही होते हैं और वे सही तरीके काम करते हैं, तो उस स्थिति को क्रोनिक ल्यूकेमिया कहा जाता है। क्रोनिक ल्यूकेमिया धीरे-धीरे खराब होता रहता है और व्यक्ति को गंभीर स्थिति तक पहुंचा देता है।

लिम्फोसाईटिक ल्यूकेमिया-
लिम्फोसाईटिक ल्यूकेमिया से तात्पर्य ऐसी स्थिति से है, जिसमें मैरो सेल सफेद ब्लड सेल बन जाते हैं।
मायलोजनस ल्यूकेमिया-
जब मौरो सेल्स लाल रक्त सेल, सफेद रक्त सेल और पेटलेट्स इत्यादि का निर्माण करते हैं, तो उसे मायोलोजनस ल्यूकेमिया कहा जाता है।

ल्यूकेमिया होने के क्या कारण हैं?
ल्यूकेमिया किसी एक कारण से नहीं होता है, बल्कि इसके बहुत सारे कारण होते हैं, जिनमें से कुछ इस प्रकार हैं-
स्मोकिंग करना
ल्यूकेमिया पर की गई काफी सारी स्टडी में यह स्पष्ट हुआ है कि ल्यूकेमिया की संभावना ऐसे लोगों में अधिक रहती है, जो स्मोकिंग करते हैं क्योंकि स्मोकिंग उनके शरीर के फंगशन पर असर डालता है।

जेनेटिक
परिवार में किसी दूसरे व्यक्ति को ल्यूकेमिया का होना- ऐसी बहुत सारी बीमारियां होती हैं, जिनका कारण जेनेटिक होता है। अत: यदि किसी परिवार में किसी व्यक्ति को ल्यूकेमिया है,तो उस परिवार के सभी सदस्यों को अपनी सेहत का विशेष ध्यान रखना चाहिए क्योंकि उन्हें भी ब्लड कैंसर हो सकता है।

कीमोथेरेपी या रेडिएशन थेरेपी का साइड-इफेक्ट्स होना
कई बार, ल्यूकेमिया कीमोथेरेपी या रेडिएशन थेरेपी के साइड-इफेक्ट्स की वजह से होती है। इसी कारण, जब कोई व्यक्ति कीमोथेरेपी या रेडिएशन थेरेपी को कराता है, तो उसे पूरी सावधानी बरतनी चाहिए और हेल्थ संबंधी किसी भी परेशानी के होने पर उसकी सूचना डॉक्टर को देनी चाहिए।
सफेद ब्लड सैल्स का बनाना
जब किसी व्यक्ति के शरीर में सफेद ब्लड सैल्स की मात्रा लाल ब्लड सैल्स से अधिक हो जाती है, तो यह ल्यूकेमिया का कारण बन जाता है।

दवाई का साइड-इफेक्ट्स का होना
कई बार, दवाईयों का सेवन भी कई सारी गंभीर बीमारियों का कारण बन जाता है। यह बात ल्यूकेमिया पर भी लागू होती है और कुछ दवाईयां इसका कारण बन जाती हैं।



Click it and Unblock the Notifications